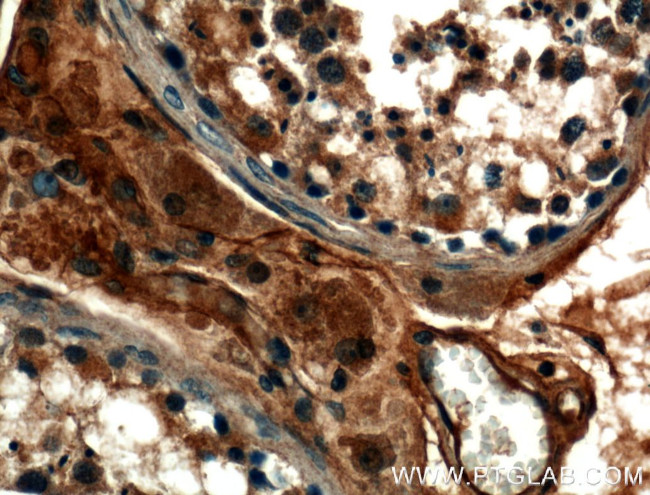
TMEM102 Antibody in Immunohistochemistry (Paraffin) (IHC (P))

Search
Proteintech
TMEM102 Polyclonal Antibody
{{$productOrderCtrl.translations['antibody.pdp.commerceCard.promotion.promotions']}}
{{$productOrderCtrl.translations['antibody.pdp.commerceCard.promotion.viewpromo']}}
{{$productOrderCtrl.translations['antibody.pdp.commerceCard.promotion.promocode']}}: {{promo.promoCode}} {{promo.promoTitle}} {{promo.promoDescription}}. {{$productOrderCtrl.translations['antibody.pdp.commerceCard.promotion.learnmore']}}
产品信息
25505-1-AP
种属反应
宿主/亚型
分类
类型
抗原
偶联物
形式
浓度
规格
纯化类型
保存液
内含物
保存条件
运输条件
产品详细信息
Immunogen sequence: MASAVWGSA PWWGPPPPAP ARPLTDIDFC SGAQLQELTQ LIQELGVQES WSDGPKPGAD LLRAKDFVFS LLGLVHRRDP RFPPQAELLL LRGGIREGSL DLGHAPLGPY ARGPHYDAGF TLLVPMFSLD GTELQLDLES CYAQVCLPEM VCGTPIREMW QDCLGPPVPG ARDSIHRTES EESSKDWQSS VDQPHSYVTE HEAPVSLEKS PSDVSASESP QHDVVDLGST APLKTMSSDV TKAAVESPVP KPSEAREAWP T (1-260 aa encoded by BC046189)
靶标信息
Selectively involved in CSF2 deprivation-induced apoptosis via a mitochondria-dependent pathway.
仅用于科研。不用于诊断过程。未经明确授权不得转售。
篇参考文献 (0)
生物信息学
蛋白别名: CBAP; Common beta-chain associated protein; DANGER family member 2B; Transmembrane protein 102; transmembrane protein 102, pseudogene; unnamed protein product
基因别名: 4632403M07Rik; CBAP; D2B; TMEM102; Tmem102-ps
UniProt ID: (Human) Q8N9M5, (Mouse) Q3UPR7
Entrez Gene ID: (Human) 284114, (Mouse) 380705